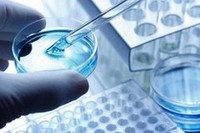
Рецензирование экспертных заключений генетической экспертизы.

Рецензирование экспертных заключений генетической экспертизы.
Нередко, в судопроизводстве или досудебном разбирательстве, возникает ситуация, когда результаты проведенной экспертизы не устраивают одну из сторон конфликта, которая расценивает выводы эксперта, как неосновательные и ложные. Кто имеет возможность оказать помощь в этом случае? Исключительно, независимый эксперт, владеющий базовыми профессиональными знаниями по части проведенной экспертизы. Путем досконального анализа экспертной и другой документации (решения суда, комментарии судьи, адвоката и др.) независимый эксперт обнаруживает ошибки и противоречивые трактования, при их наличии. Высокая квалификация и специальные познания эксперта дают возможность обнаружить нюансы, относящиеся к противоречиям и расхождениям, проведенной экспертизы, с требованиями методик, инструкций и законов.
Судья, адвокат не обладают знаниями, достаточными для профессиональной оценки проведенной экспертизы. В силу этого, они не могут сделать выводы об обоснованности заключения эксперта, безошибочности подбора экспертных методик, сообразности избранных методик новейшим достижениям науки в исследуемом вопросе. Рецензирование не содержит повторения первоначальной экспертизы, поэтому ее направленность формальная. Тем не менее, независимый эксперт может определить логику в изложении материала, безошибочность отбора материала, взаимообусловленность выводов эксперта с результатами исследования, соответствие этапов экспертного исследования требованиям Российского законодательства. При производстве рецензии, эксперт не может установить, насколько преднамеренно были предоставлены нелогичные, противоречивые результаты. Тем не менее, он может обратить внимание на низкий уровень квалификации эксперта, на выборочное утаивание результатов исследования, на отступление от методик при экспертном исследовании.
При проведении рецензии генетической экспертизы обнаруживается определенная категория недостатков:
1. ошибочный подбор методик экспертных исследований, не соответствующий современным достижениям науки в данном вопросе;
2. несоблюдение процессуального порядка назначения и производства экспертного исследования, отклонения от методик или законодательства при выполнении экспертизы;
3. неверная идентификация признаков материалов и предметов;
4. частичное скрытие результатов;
5. неполнота и нелогичность изъяснения в заключении эксперта;
6. низкая осведомленность эксперта в вопросах узкой специализации.
Вопросы для эксперта при проведении рецензирования:
1. подтвердить или опровергнуть верность, принятой экспертом, методики для решения назначенной задачи;
2. отображает ли принятая методика современные научные знания по данному предмету исследования?
3. согласуется ли процедура проведения экспертизы с методикой проведения генетической экспертизы ДНК?
4. выявлены ли несоответствия между выводами экспертизы и ее исследовательской частью?
5. использовались ли при проведении экспертного исследования, исключительно, действующие в настоящее время, законодательные и нормативные акты?
Для более полных консультаций по всем, возникающим у Вас вопросам, обращайтесь в НП «СРО судебных экспертов».
26.01.2015


Комментарии